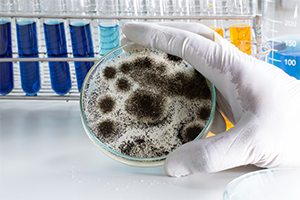
mold-test

residential and COMMERCIAL
Certified Allergen Testing
Allergens aren’t always visible—but that doesn’t mean they aren’t harming the air you breathe. Our certified allergen testing helps you identify hidden irritants, confirm safety, and plan effective mitigation for homes and businesses
Why Test For Allergens?
Allergens like dust mites, pet dander, mold spores, pollen, and other airborne particles can aggravate allergies, asthma, and respiratory conditions. While many symptoms are obvious, only professionals can collect and analyze samples to pinpoint the source and severity of your indoor air allergen load.
- Occupants suffer from persistent allergies or asthma
- You experience unexplained respiratory symptoms
- You're preparing a property for sale, rental, or occupancy
- You’ve recently made changes—new HVAC, renovations, or pets
- You want peace of mind before buying, selling, or renting a property

What You Get With Bio Safe Air
Our Certified Allergen Testing Process

Inspection
Our inspectors evaluate potential allergen sources—HVAC systems, dust reservoirs, pet zones, and moisture-prone spaces.

Take Samples
We collect lab-quality samples from the air and surfaces using industry-approved protocols designed to detect common airborne allergens.
Lab Analysis
Samples are submitted to accredited labs for detailed quantification of allergen types and concentrations.

Action Plan
You’ll receive a clear, easy-to-understand report with test results, interpretation, and customized recommendations to reduce allergens in your environment.

0+
Years of experience
Don’t Wait for Mold to Spread
Testing Frequently Asked Questions
Pricing depends on the number of samples and the size of your space. Please call for a custom quote.
Most reports are delivered within 48–72 hours.
No — the process is non-invasive and quick. We take precautions to minimize disruption.
We’ll walk you through remediation strategies—like deep cleaning, HVAC filtering upgrades, humidity control, or targeted removal—and help you decide on next steps.
residential and COMMERCIAL
Protect Your Health & Indoor Air Quality
Allergens affect us even when we can't see them. Timely testing protects your health, your property, and gives you a clear path for a cleaner indoor environment. Contact us today to book your certified allergen test.
